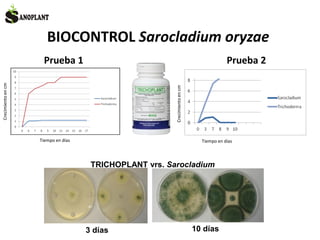
BIOCONTROL Sarocladium oryzae
Crecimientoencm
Tiempo en días
Crecimientoencm
Tiempo en días
TRICHOPLANT vrs. Sarocladium
Prueba 1 Prueba 2
3 días 10 días

Este documento resume las principales enfermedades que afectan el cultivo del arroz y sus condiciones de desarrollo, así como el control biológico de estas utilizando productos como Trichoplant. Describe enfermedades causadas por ácaros, hongos como Sarocladium oryzae, Gaeumannomyces graminis, Rhizoctonia solani y bacterias como Pseudomonas. Explica el control de enfermedades como el vaneamiento mediante el tratamiento de la semilla con Trichoplant y su efecto positivo en el cre